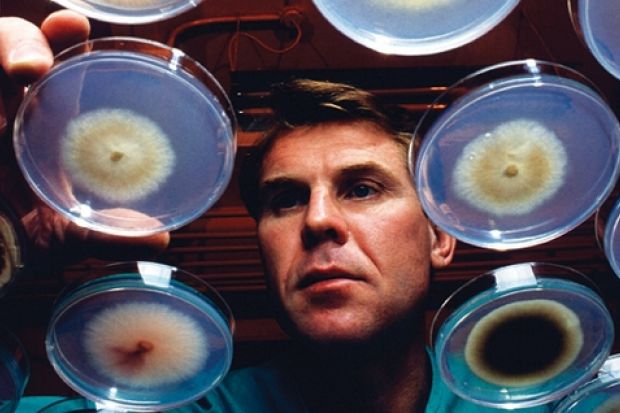

The European Union's research budget has hit a record high, including a major increase for funding for blue-skies research.
The latest round of annual funding from the European Commission's Seventh Framework Programme will see overall spending increase by more than 9 per cent to €7 billion (£6.2 billion).
Funding for the highly regarded European Research Council, which finances "frontier" research, will rise by 23 per cent to €1.6 billion.
Jerzy Langer, professor of physics at the Polish Academy of Sciences, said that in terms of money received versus investment, UK researchers were the "true financial winners".
Commenting on the considerable increase in funding for the ERC, he said it was "a triple miracle".
"Scientists have finally united around (the council), politicians have listened to the arguments of scientists and they have also given away so much money without any guarantee about the return to their constituencies," he added.
Richard Jones, pro vice-chancellor for research and innovation at the University of Sheffield, also saw the UK as a major winner from the settlement. "The UK has historically done rather well from ERC funds, so this is good news for us in an environment in which our own research councils' funding is being squeezed," he said.
"As an organisation devoted to funding science on the basis of excellence alone, it's an important complement to the more goal-orientated research funded by the rest of the framework programme."
Luke Georghiou, vice-president for research and innovation at the University of Manchester, said that ERC-funded research was now considered "the gold standard", adding that the relative lack of bureaucracy involved was particularly welcome.
Others also pointed to the strong results yielded by ERC funding.
Andrea Ferrari, reader in nanotechnology at the University of Cambridge, who was awarded an ERC grant in 2007, said: "Konstantin Novoselov (professor of physics at Manchester), who won the Nobel Prize in Physics in 2010, was able to conduct his basic research thanks to the nature of the ERC grants.
"This was a huge immediate success for the ERC idea, showing their ability to spot and reward talent, unlike other EU grants, where politics plays a significant role."
Funding for Marie Curie Fellowships, which researchers can take anywhere within the EU, will also rise by 17 per cent to €900 million. The number of fellowships will increase from 7,000 to 10,000.
The allocation to Marie Curie Action, which oversees the fellowships, will include €20 million for a pilot project to fund European industrial doctorates, intended to stimulate entrepreneurship and cooperation between universities, research institutions and companies.
Máire Geoghegan-Quinn, commissioner for research, innovation and science, said the increase in funding was tied to the EU's Innovation Union strategy to help Europe keep pace with a boom in research activity in the US and China.
About 174,000 jobs in the short term and nearly 450,000 jobs and €80 billion in GDP growth in the longer term would be created from the investment package over the next 15 years, she said.
"Many member states...are increasing public investment in research and innovation. There is consensus that this is the route to sustainable growth and jobs, providing the light at the end of the dark economic tunnel."
In total, more than 16,000 funding recipients will benefit from the settlement.
Earlier this month the commission announced ambitious plans to boost research funding by 46 per cent over the next framework programme, which begins in 2014.
The 2014-2020 package will be worth €80 billion. Funding levels for universities and science have yet to be announced, but Ms Geoghegan-Quinn has said she will argue for an increase in funding for the ERC, which was allocated €7.5 billion for the period 2007-13.
Register to continue
Why register?
- Registration is free and only takes a moment
- Once registered, you can read 3 articles a month
- Sign up for our newsletter
Subscribe
Or subscribe for unlimited access to:
- Unlimited access to news, views, insights & reviews
- Digital editions
- Digital access to THE’s university and college rankings analysis
Already registered or a current subscriber?